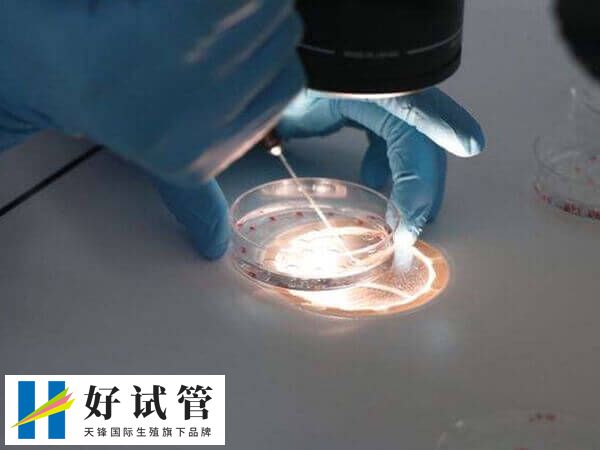
养囊成功的个数因人而异

5个受精卵能养囊几个
通常情况下,5个受精卵有可能培养形成2到3个囊胚,如果患者的受精卵质量较差,或是发育潜力较低,那么养囊成功的胚胎数量可能在1-2个左右,具体还要以实际为准。毕竟养囊胚的过程受到多种因素的影响,包括卵子和精子的质量,以及实验室条件和医生的操作技术。
五个受精卵胚胎养囊的数量
囊胚培养是指在试管婴儿的治疗中,将胚胎培养到囊胚阶段,一般囊胚培养需要很高的条件,并非所有卵裂期胚胎都能培养成囊胚,只有高质量的胚胎有相对较大的机会发育成囊胚,所以五个受精卵胚胎养囊的数量多少,如下所示:
1-2个
五个受精卵胚胎正常可以培养1-2个囊胚,但具体情况可能因实验室技术和胚胎质量而异,如果患者在囊胚培养过程中,有一部分胚胎出现发育潜能不足,那么也就无法养成囊胚了。
3-4个
如果患者五个受精卵胚胎的质量都比较好情况下,并且是由高水准的实验室和医生进行养囊,那么最后五个受精卵胚胎能培养3-4个囊胚。
五个受精卵胚胎可以养囊成功的个数因人而异,毕竟囊胚培养的过程也是适者生存的过程。另外,也并非所有的患者都可以进行养囊,因此建议患者在养囊前,最好根据个体情况及医生的建议下,再选择是否养囊比较好。
正常五个受精养囊的成功率
在实际试管养囊操作过程中,因养囊是优生劣汰的培养过程,所以正常五个受精的胚胎,其养囊成功率并无固定标准。如果患者正常受精五个的受精卵胚胎,其质量属于优质的情况下,那么养囊成功率可能在40%-50%左右,反之如果五个受精卵质量都不比较差,那么养囊成功率会降低,大概低至10%-20%都是有可能的。

另外,还要了解的是,如果正常五个受精胚胎,为一级和二级质量的胚胎,那么养囊成功率约为50%,如果是三级胚胎的成功率稍低,三级胚胎养囊成功的希望大约在30%-40%之间,甚至也可能会更低。同时养囊实验室技术不同,那么养囊的成功率也会有所差异,通常经验丰富的技术人员和良好的实验室环境可以提高养囊的成功率,所以建议大家养囊时,要注意多个方面再决定养囊,这样养囊的成功率才比较高。





